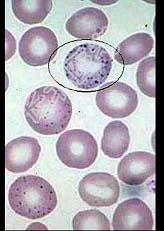

试题详情
- 单项选择题图中所示红细胞异常结构为 ( )
A、H-J小体
B、杜勒小体
C、嗜碱性点彩红细胞
D、疟原虫
E、网织红细胞
关注下方微信公众号,搜题查看答案

热门试题
- 网织红细胞的临床意义,描述正确的是A、放
- 下列与获得性血友病患者发病的相关因素有(
- 患儿男,6岁。易倦,紫癜月余,脾肋下2c
- 检测PT用的样本是A、全血B、乏血小板血
- 如图,圈中所示红细胞中的异常结构为 (
- 导致血小板输注无效的免疫因素包括A、HL
- 临床上常用的细胞化学染色固定方法是 (
- 下列有关浆细胞白血病的描述正确的是 (
- 下列关于造血祖细胞培养的临床应用,叙述错
- 图中所示为一异常形态红细胞,下列说法错误
- 与慢性系统性疾病贫血相符的是 (
- 患儿,8个月, 米糕喂养,长期腹泻, 血
- 多毛细胞白血病的临床特点,下列哪一条不正
- 出血时间缩短常见于 ( )A、血
- 某患者外周血涂片如图,请问下列哪种是促成
- 患者,男性, 32,发烧伴牙龈出血5天,
- 有关血小板聚集试验哪些说法是对的 (
- 以下支持原发性纤溶亢进的指标包括(
- 男性,30岁,血管性血友病,凝血因子Ⅷ活
- 原发免疫性血小板减少症的发病机制包括(